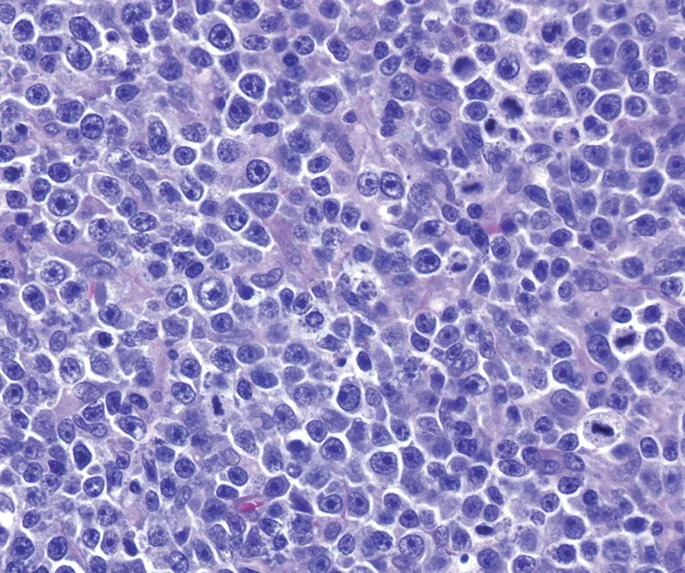
DLBCL Histopathology: Large Atypical Lymphocytes

NHL Classification - The Lymphoma Lineup
- Primary Division: B-cell neoplasms (
85%) vs. T-cell/NK-cell neoplasms (15%). - Clinical Behavior:
- Indolent (Slow): Waxing & waning course. E.g., Follicular, Marginal Zone, SLL.
- Aggressive (Fast): Rapidly fatal without treatment. E.g., DLBCL, Burkitt, Mantle Cell.
ā SLL vs. CLL: Small Lymphocytic Lymphoma (SLL) and Chronic Lymphocytic Leukemia (CLL) are the same disease. The diagnosis is CLL if peripheral blood absolute lymphocyte count is >5,000/μL; otherwise, it's SLL.
Indolent B-Cell NHL - The Slowpokes
- Follicular Lymphoma: Most common indolent type.
- Genetic hallmark: t(14;18) translocation ā BCL2 overexpression (inhibits apoptosis).
- Presents with waxing and waning, painless peripheral lymphadenopathy.
- Histology: Nodule-like pattern of packed follicles.
- Risk of transformation to aggressive DLBCL.
- Marginal Zone Lymphoma: Linked to chronic inflammation (e.g., H. pylori ā MALT lymphoma).
- Small Lymphocytic Lymphoma (SLL): Tissue version of CLL; defined by <5,000 circulating monoclonal B-cells/µL.

ā The t(14;18) translocation juxtaposes the BCL2 gene with the immunoglobulin heavy chain (IgH) enhancer, driving overexpression and preventing apoptosis in follicular lymphoma cells.
Aggressive B-Cell NHL - The Fast & Furious
- Diffuse Large B-Cell Lymphoma (DLBCL): Most common NHL, often a rapidly enlarging mass. Can arise de novo or from indolent lymphoma transformation. Treat with R-CHOP.
- Burkitt Lymphoma: Extremely aggressive, linked to EBV.
- Genetics: t(8;14) translocation of the c-myc gene.
- Histology: Classic "starry sky" pattern.
- Mantle Cell Lymphoma: Aggressive course, poor prognosis.
- Genetics: t(11;14) causes Cyclin D1 overexpression, driving the G1/S phase.
ā The "starry sky" in Burkitt's is formed by tingible body macrophages (stars) engulfing apoptotic tumor cells amidst a sheet of dark, uniform lymphoid cells (sky).
T-Cell Lymphomas - Cutaneous Creeps
- Mycosis Fungoides (MF): Most common cutaneous T-cell lymphoma (CTCL).
- Indolent course; progresses from patch ā plaque ā tumor stage.
- Histology: Pautrier's microabscesses-intraepidermal nests of neoplastic CD4+ T-cells with cerebriform nuclei.

- SƩzary Syndrome: A leukemic, aggressive variant of CTCL.
ā Presents with a classic triad: generalized erythroderma (the "red man"), diffuse lymphadenopathy, and circulating malignant SĆ©zary cells.
- Adult T-cell Leukemia/Lymphoma (ATLL):
- Caused by HTLV-1; common in Japan, Caribbean.
- Features: lytic bone lesions (ā hypercalcemia), skin lesions, hepatosplenomegaly.
- Characteristic "flower cells" on blood smear.
Diagnosis & Staging - The NHL Workup
- Biopsy: Excisional biopsy is the gold standard for diagnosis, providing tissue architecture crucial for subtyping. Avoids sampling error of FNA.
- Labs: āLDH correlates with tumor burden and is a key prognostic factor in the IPI score.
- Staging: Ann Arbor system (I-IV) determines disease extent. Stage is the most important prognostic factor.
ā PET/CT is now standard for staging aggressive lymphomas like DLBCL, assessing treatment response, and detecting relapse.
- More common than Hodgkin, NHL presents with widespread, non-contiguous lymphadenopathy and extranodal disease.
- Burkitt Lymphoma: t(8;14) (c-myc), "starry-sky" histology, EBV association.
- Diffuse Large B-cell Lymphoma (DLBCL): Most common NHL in adults, very aggressive.
- Follicular Lymphoma: t(14;18) (BCL-2 overexpression), indolent course, can transform to DLBCL.
- Mantle Cell Lymphoma: t(11;14) (Cyclin D1), aggressive with a poor prognosis.
- Marginal Zone Lymphoma: Arises from chronic inflammation (e.g., H. pylori gastritis).
Unlock the full lesson and continue reading
Signup to continue reading this lesson and unlimited access questions, flashcards, AI notes, and more